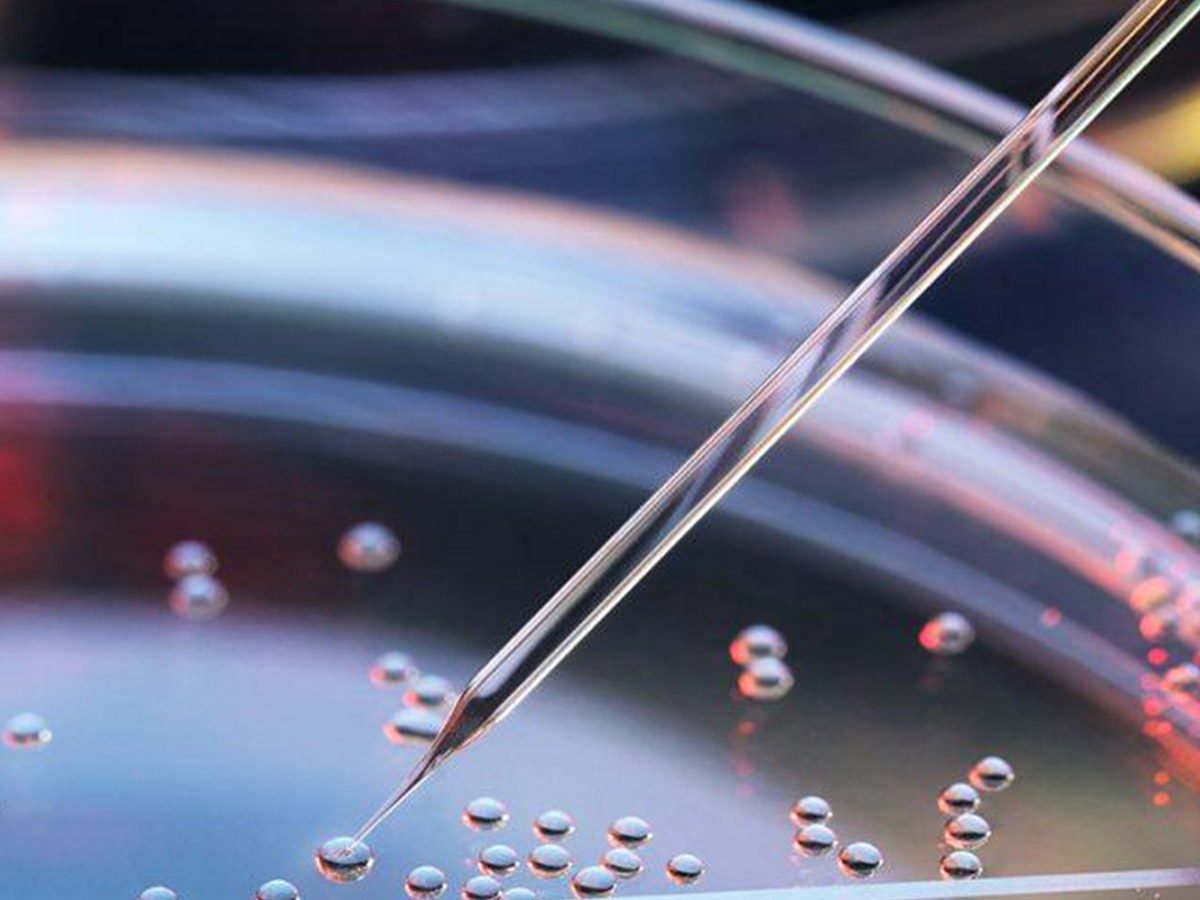

ChiesaMondo
ChiesaMondo
Francia: revisione della legge sulla procreazione medicalmente assistita. Vescovi: “Istituisce l’assenza del padre”
A essere oggetto di revisione è una serie di questioni bioetiche, oltre alla procreazione medicalmente assistita (Pma), come ad esempio la donazione di organi o la ricerca sulle cellule staminali embrionali. Il punto di maggiore novità (e dibattito al momento) è l’apertura della Pma a “qualsiasi coppia formata da un uomo e una donna, o due donne o qualsiasi donna non sposata”, rimborsabile dal servizio sanitario nazionale, e il fatto che si sleghi il ricorso alla procreazione assistita dal criterio dell’infertilità. Altro punto delicato, il diritto all’anonimato del donatore. Senza porre un limite definito al numero di embrioni fecondati in vitro, la loro sorte, nel caso non vengano impiantati, è comunque nelle mani dei genitori/della genitrice